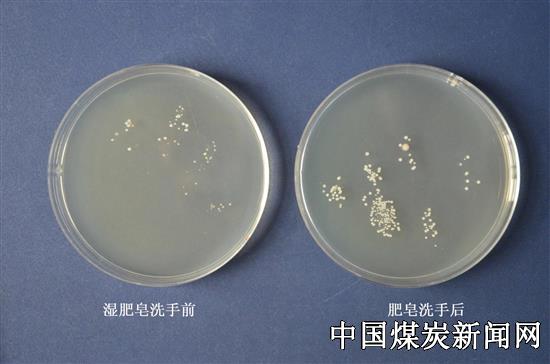
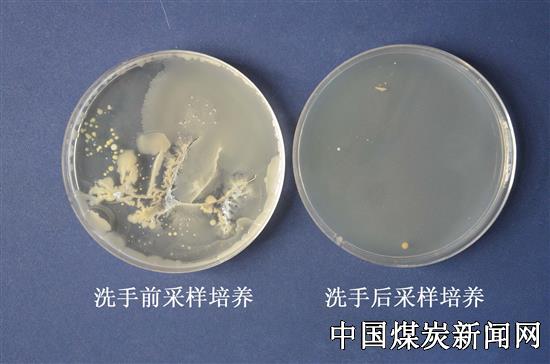

首页
总揽
写作
简讯
散文
诗词
摄影
幻灯片
书画展
局矿快报
党群工作
安全专题
经验交流
通讯特写
厂商在线
领导访谈
论文读书
人物展示
图片新闻
安监动态
矿业新闻
焦点话题
事故快报
小说故事杂文
在线投稿 |
特约通讯员档案
| 冀中能源峰峰集团总医院院感科在“世界手卫生日”通过手卫生前后培养对照试验开展宣教活动 | |||
| 煤炭资讯网 | 2016/5/10 12:15:19 经验交流 | ||
|
“您好,王主任,今天是“世界手卫生日”,我们正在做手卫生前后培养对照试验,请您配合我们采样。” 冀中能源峰峰集团总医院医院感染管理科主任李超带领科室成员在该院病房对ICU主任王云辉说,王主任说:“好,不洗手我手上的多重耐药细菌一定很多!”
  5月5日,总医院医院感染管理科工作人员利用世界手卫生日,开展“关注手部卫生,保障外科安全”宣教活动。
每年5月5日,是“世界手卫生日”,由世界卫生组织(WHO)于2009年倡议发起,旨在强调在医疗护理过程中提高医护人员手部卫生、减少医源性感染的重要性。这天,该院医院感染管理科深入到检验科、烧伤科、胸外科、重症医学科等十七个科室,现场对34名医护人员工作时手卫生前后情况进行采样,通过微生物室的培养,把洗手前后菌培养情况两相对照进行宣教展示。培养一天后,大家看到手卫生前采集的培养皿上细菌大量繁殖,洗手后的采样培养皿上基本上非常干净。通过手卫生前后培养结果的巨大反差,直观的让医护人员认识到手卫生对院感控制的重要性。
 
| |||
声明:本网站新闻版权归煤炭资讯网与作者共同所有,任何网络媒体或个人转载,必须注明“来源:煤炭资讯网(www.cwestc.com)及其原创作者”,否则本网将保留追究其相关法律责任的权利。转载是出于传递更多信息之目的,若本网转载有来源标注错误或侵犯了您的合法权益,请作者持权属证明与本网联系(本网通讯员除外),我们将及时更正、删除,谢谢。 邮箱地址:1017016419@qq.com